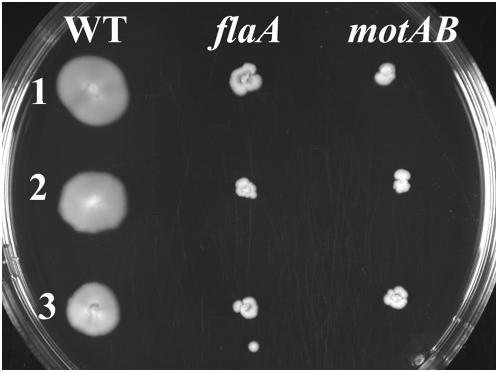
https://cdn.ncbi.nlm.nih.gov/pmc/blobs/6061/2664462/fd38a2b6ce3b/pone.0005142.g001.jpg

食源性病原体单核细胞增生李斯特菌的不同菌株利用鞭毛和运动性进行植物定殖及适应环境。
The use of flagella and motility for plant colonization and fitness by different strains of the foodborne pathogen Listeria monocytogenes.
作者信息
Gorski Lisa, Duhé Jessica M, Flaherty Denise
机构信息
US Department of Agriculture, Produce Safety and Microbiology Research Unit, Agricultural Research Service, Albany, California, United States of America.
出版信息
PLoS One. 2009;4(4):e5142. doi: 10.1371/journal.pone.0005142. Epub 2009 Apr 9.
The role of flagella and motility in the attachment of the foodborne pathogen Listeria monocytogenes to various surfaces is mixed with some systems requiring flagella for an interaction and others needing only motility for cells to get to the surface. In nature this bacterium is a saprophyte and contaminated produce is an avenue for infection. Previous studies have documented the ability of this organism to attach to and colonize plant tissue. Motility mutants were generated in three wild type strains of L. monocytogenes by deleting either flaA, the gene encoding flagellin, or motAB, genes encoding part of the flagellar motor, and tested for both the ability to colonize sprouts and for the fitness of that colonization. The motAB mutants were not affected in the colonization of alfalfa, radish, and broccoli sprouts; however, some of the flaA mutants showed reduced colonization ability. The best colonizing wild type strain was reduced in colonization on all three sprout types as a result of a flaA deletion. A mutant in another background was only affected on alfalfa. The third, a poor alfalfa colonizer was not affected in colonization ability by any of the deletions. Fitness of colonization was measured in experiments of competition between mixtures of mutant and parent strains on sprouts. Here the flaA and motAB mutants of the three strain backgrounds were impaired in fitness of colonization of alfalfa and radish sprouts, and one strain background showed reduced fitness of both mutant types on broccoli sprouts. Together these data indicate a role for flagella for some strains to physically colonize some plants, while the fitness of that colonization is positively affected by motility in almost all cases.
食源性病原体单核细胞增生李斯特菌的鞭毛和运动性在其附着于各种表面的过程中所起的作用较为复杂,有些系统需要鞭毛来介导相互作用,而另一些系统则仅需运动性就能使细胞到达表面。在自然界中,这种细菌是腐生菌,受污染的农产品是其感染途径。先前的研究已证明该生物体能够附着并定殖于植物组织。通过缺失编码鞭毛蛋白的基因flaA或编码鞭毛马达部分的基因motAB,在单核细胞增生李斯特菌的三株野生型菌株中产生了运动性突变体,并对其定殖于豆芽的能力以及该定殖的适应性进行了测试。motAB突变体在苜蓿、萝卜和西兰花芽苗菜的定殖过程中未受影响;然而,一些flaA突变体显示出定殖能力下降。由于flaA缺失,定殖能力最佳的野生型菌株在所有三种芽苗菜类型上的定殖均减少。另一背景下的一个突变体仅在苜蓿上受到影响。第三个,即苜蓿定殖能力较差的菌株,其定殖能力未受任何缺失的影响。通过突变体与亲本菌株混合物在芽苗菜上的竞争实验来测定定殖适应性。在此,三种菌株背景的flaA和motAB突变体在苜蓿和萝卜芽苗菜的定殖适应性方面受损,并且一种菌株背景显示两种突变体类型在西兰花芽苗菜上的适应性均降低。这些数据共同表明,对于某些菌株而言,鞭毛在物理上定殖于某些植物方面发挥作用,而在几乎所有情况下,运动性对该定殖的适应性具有积极影响。